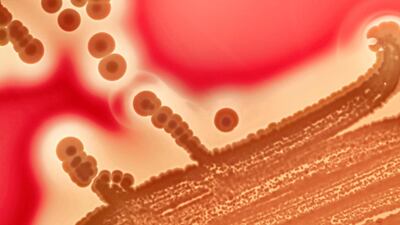
Antibiotic overuse poses a genuine threat today. Getty

I refer to Olivier Oullier's opinion piece We can all do our bit to stop antibiotic overuse (April 25): this meaningful and thought-provoking article on the overuse of antibiotics in the UK and worldwide documents succintly how the medical profession and particularly general practitioners are relying far too heavily on antibiotics. This happens even when, in cases of virus for instance, they are utterly ineffective. Today antibiotics have become more resistant, in spite of so many new discoveries from the pharmaceutical industry. Now more than ever, it is important that we do not take antibiotics when we have no genuine need for them.
K Ragavan, Bangalore
Sport rule is sure to be a win-win for all involved
I write in reference to your online article President Sheikh Khalifa passes decree paving way for expats to represent UAE sports teams (April 25): this is big news. I can already see the Olympic gold medals coming our way.
Mansoor Al Obeidli, Abu Dhabi
Thank you Sheikh Khalifa, for valuing expatriate talent.
Name withheld by request
We need laws to protect our endangered bird species
I refer to your article How illegal bird hunting in the Arab world could drive species to extinction (March 25): we need basic rules and regulations that are properly enforced if we are to tackle this problem. But more importantly in my view, basic environmental education in schools is a must.
Name withheld by request
Social media has tangible benefits for small businesses
In reference to your article UAE General Assembly calls for tighter grip on social media influencers and their content (April 25), we should remember that many social media influencers are entrepreneurs. While I dislike influencers because they blur the line between regular social engagement and brand advertising, we should remember that social media has been great for allowing people like personal trainers to advertise. It is not used exclusively to push products.
Chris Reid, Dubai
While you're here
ITU Abu Dhabi World Triathlon
For more information go to www.abudhabi.triathlon.org.
T20 WORLD CUP QUALIFIERS
Qualifier A, Muscat
(All matches to be streamed live on icc.tv)
Fixtures
Friday, February 18: 10am Oman v Nepal, Canada v Philippines; 2pm Ireland v UAE, Germany v Bahrain
Saturday, February 19: 10am Oman v Canada, Nepal v Philippines; 2pm UAE v Germany, Ireland v Bahrain
Monday, February 21: 10am Ireland v Germany, UAE v Bahrain; 2pm Nepal v Canada, Oman v Philippines
Tuesday, February 22: 2pm Semi-finals
Thursday, February 24: 2pm Final
UAE squad:Ahmed Raza(captain), Muhammad Waseem, Chirag Suri, Vriitya Aravind, Rohan Mustafa, Kashif Daud, Zahoor Khan, Alishan Sharafu, Raja Akifullah, Karthik Meiyappan, Junaid Siddique, Basil Hameed, Zafar Farid, Mohammed Boota, Mohammed Usman, Rahul Bhatia
While you're here
Hussein Ibish: Could it be game over for Donald Trump?
Joyce Karam: Trump's campaign thrown off balance
Trump tests positive: everything we know so far
While you're here
National Editorial: Covid-hit India needs the world's solidarity and support
Rebecca Bundhun: Covid-19 jeopardising education of millions in India
Chitrabhanu Kadalayil: Is India's federalism facing needless stress tests?
Johann Chacko: What Kerala can teach us all about flattening the curve
Kunal Purohit: India's migrant labour crisis is a chance to fix an old wrong
Mercer, the investment consulting arm of US services company Marsh & McLennan, expects its wealth division to at least double its assets under management (AUM) in the Middle East as wealth in the region continues to grow despite economic headwinds, a company official said.
Mercer Wealth, which globally has $160 billion in AUM, plans to boost its AUM in the region to $2-$3bn in the next 2-3 years from the present $1bn, said Yasir AbuShaban, a Dubai-based principal with Mercer Wealth.
“Within the next two to three years, we are looking at reaching $2 to $3 billion as a conservative estimate and we do see an opportunity to do so,” said Mr AbuShaban.
Mercer does not directly make investments, but allocates clients’ money they have discretion to, to professional asset managers. They also provide advice to clients.
“We have buying power. We can negotiate on their (client’s) behalf with asset managers to provide them lower fees than they otherwise would have to get on their own,” he added.
Mercer Wealth’s clients include sovereign wealth funds, family offices, and insurance companies among others.
From its office in Dubai, Mercer also looks after Africa, India and Turkey, where they also see opportunity for growth.
Wealth creation in Middle East and Africa (MEA) grew 8.5 per cent to $8.1 trillion last year from $7.5tn in 2015, higher than last year’s global average of 6 per cent and the second-highest growth in a region after Asia-Pacific which grew 9.9 per cent, according to consultancy Boston Consulting Group (BCG). In the region, where wealth grew just 1.9 per cent in 2015 compared with 2014, a pickup in oil prices has helped in wealth generation.
BCG is forecasting MEA wealth will rise to $12tn by 2021, growing at an annual average of 8 per cent.
Drivers of wealth generation in the region will be split evenly between new wealth creation and growth of performance of existing assets, according to BCG.
Another general trend in the region is clients’ looking for a comprehensive approach to investing, according to Mr AbuShaban.
“Institutional investors or some of the families are seeing a slowdown in the available capital they have to invest and in that sense they are looking at optimizing the way they manage their portfolios and making sure they are not investing haphazardly and different parts of their investment are working together,” said Mr AbuShaban.
Some clients also have a higher appetite for risk, given the low interest-rate environment that does not provide enough yield for some institutional investors. These clients are keen to invest in illiquid assets, such as private equity and infrastructure.
“What we have seen is a desire for higher returns in what has been a low-return environment specifically in various fixed income or bonds,” he said.
“In this environment, we have seen a de facto increase in the risk that clients are taking in things like illiquid investments, private equity investments, infrastructure and private debt, those kind of investments were higher illiquidity results in incrementally higher returns.”
The Abu Dhabi Investment Authority, one of the largest sovereign wealth funds, said in its 2016 report that has gradually increased its exposure in direct private equity and private credit transactions, mainly in Asian markets and especially in China and India. The authority’s private equity department focused on structured equities owing to “their defensive characteristics.”
The more serious side of specialty coffee
While the taste of beans and freshness of roast is paramount to the specialty coffee scene, so is sustainability and workers’ rights.
The bulk of genuine specialty coffee companies aim to improve on these elements in every stage of production via direct relationships with farmers. For instance, Mokha 1450 on Al Wasl Road strives to work predominantly with women-owned and -operated coffee organisations, including female farmers in the Sabree mountains of Yemen.
Because, as the boutique’s owner, Garfield Kerr, points out: “women represent over 90 per cent of the coffee value chain, but are woefully underrepresented in less than 10 per cent of ownership and management throughout the global coffee industry.”
One of the UAE’s largest suppliers of green (meaning not-yet-roasted) beans, Raw Coffee, is a founding member of the Partnership of Gender Equity, which aims to empower female coffee farmers and harvesters.
Also, globally, many companies have found the perfect way to recycle old coffee grounds: they create the perfect fertile soil in which to grow mushrooms.
More from this story
The burning issue
The internal combustion engine is facing a watershed moment – major manufacturer Volvo is to stop producing petroleum-powered vehicles by 2021 and countries in Europe, including the UK, have vowed to ban their sale before 2040. The National takes a look at the story of one of the most successful technologies of the last 100 years and how it has impacted life in the UAE.
Read part four: an affection for classic cars lives on
Read part three: the age of the electric vehicle begins
Read part two: how climate change drove the race for an alternative
Ibrahim's play list
Completed an electrical diploma at the Adnoc Technical Institute
Works as a public relations officer with Adnoc
Apart from the piano, he plays the accordion, oud and guitar
His favourite composer is Johann Sebastian Bach
Also enjoys listening to Mozart
Likes all genres of music including Arabic music and jazz
Enjoys rock groups Scorpions and Metallica
Other musicians he likes are Syrian-American pianist Malek Jandali and Lebanese oud player Rabih Abou Khalil
New schools in Dubai
How to apply for a drone permit
- Individuals must register on UAE Drone app or website using their UAE Pass
- Add all their personal details, including name, nationality, passport number, Emiratis ID, email and phone number
- Upload the training certificate from a centre accredited by the GCAA
- Submit their request
What are the regulations?
- Fly it within visual line of sight
- Never over populated areas
- Ensure maximum flying height of 400 feet (122 metres) above ground level is not crossed
- Users must avoid flying over restricted areas listed on the UAE Drone app
- Only fly the drone during the day, and never at night
- Should have a live feed of the drone flight
- Drones must weigh 5 kg or less
England's lowest Test innings
- 45 v Australia in Sydney, January 28, 1887
- 46 v West Indies in Port of Spain, March 25, 1994
- 51 v West Indies in Kingston, February 4, 2009
- 52 v Australia at The Oval, August 14, 1948
- 53 v Australia at Lord's, July 16, 1888
- 58 v New Zealand in Auckland, March 22, 2018
Plastic tipping points
Ten tax points to be aware of in 2026
1. Domestic VAT refund amendments: request your refund within five years
If a business does not apply for the refund on time, they lose their credit.
2. E-invoicing in the UAE
Businesses should continue preparing for the implementation of e-invoicing in the UAE, with 2026 a preparation and transition period ahead of phased mandatory adoption.
3. More tax audits
Tax authorities are increasingly using data already available across multiple filings to identify audit risks.
4. More beneficial VAT and excise tax penalty regime
Tax disputes are expected to become more frequent and more structured, with clearer administrative objection and appeal processes. The UAE has adopted a new penalty regime for VAT and excise disputes, which now mirrors the penalty regime for corporate tax.
5. Greater emphasis on statutory audit
There is a greater need for the accuracy of financial statements. The International Financial Reporting Standards standards need to be strictly adhered to and, as a result, the quality of the audits will need to increase.
6. Further transfer pricing enforcement
Transfer pricing enforcement, which refers to the practice of establishing prices for internal transactions between related entities, is expected to broaden in scope. The UAE will shortly open the possibility to negotiate advance pricing agreements, or essentially rulings for transfer pricing purposes.
7. Limited time periods for audits
Recent amendments also introduce a default five-year limitation period for tax audits and assessments, subject to specific statutory exceptions. While the standard audit and assessment period is five years, this may be extended to up to 15 years in cases involving fraud or tax evasion.
8. Pillar 2 implementation
Many multinational groups will begin to feel the practical effect of the Domestic Minimum Top-Up Tax (DMTT), the UAE's implementation of the OECD’s global minimum tax under Pillar 2. While the rules apply for financial years starting on or after January 1, 2025, it is 2026 that marks the transition to an operational phase.
9. Reduced compliance obligations for imported goods and services
Businesses that apply the reverse-charge mechanism for VAT purposes in the UAE may benefit from reduced compliance obligations.
10. Substance and CbC reporting focus
Tax authorities are expected to continue strengthening the enforcement of economic substance and Country-by-Country (CbC) reporting frameworks. In the UAE, these regimes are increasingly being used as risk-assessment tools, providing tax authorities with a comprehensive view of multinational groups’ global footprints and enabling them to assess whether profits are aligned with real economic activity.
Contributed by Thomas Vanhee and Hend Rashwan, Aurifer
Global Fungi Facts
• Scientists estimate there could be as many as 3 million fungal species globally
• Only about 160,000 have been officially described leaving around 90% undiscovered
• Fungi account for roughly 90% of Earth's unknown biodiversity
• Forest fungi help tackle climate change, absorbing up to 36% of global fossil fuel emissions annually and storing around 5 billion tonnes of carbon in the planet's topsoil
THE BIO
Born: Mukalla, Yemen, 1979
Education: UAE University, Al Ain
Family: Married with two daughters: Asayel, 7, and Sara, 6
Favourite piece of music: Horse Dance by Naseer Shamma
Favourite book: Science and geology
Favourite place to travel to: Washington DC
Best advice you’ve ever been given: If you have a dream, you have to believe it, then you will see it.
Farage on Muslim Brotherhood
Nigel Farage told Reform's annual conference that the party will proscribe the Muslim Brotherhood if he becomes Prime Minister.
"We will stop dangerous organisations with links to terrorism operating in our country," he said. "Quite why we've been so gutless about this – both Labour and Conservative – I don't know.
“All across the Middle East, countries have banned and proscribed the Muslim Brotherhood as a dangerous organisation. We will do the very same.”
It is 10 years since a ground-breaking report into the Muslim Brotherhood by Sir John Jenkins.
Among the former diplomat's findings was an assessment that “the use of extreme violence in the pursuit of the perfect Islamic society” has “never been institutionally disowned” by the movement.
The prime minister at the time, David Cameron, who commissioned the report, said membership or association with the Muslim Brotherhood was a "possible indicator of extremism" but it would not be banned.
How does ToTok work?
The calling app is available to download on Google Play and Apple App Store
To successfully install ToTok, users are asked to enter their phone number and then create a nickname.
The app then gives users the option add their existing phone contacts, allowing them to immediately contact people also using the application by video or voice call or via message.
Users can also invite other contacts to download ToTok to allow them to make contact through the app.
Essentials
The flights
Emirates flies direct from Dubai to Seattle from Dh6,755 return in economy and Dh24,775 in business class.
The cruise
UnCruise Adventures offers a variety of small-ship cruises in Alaska and around the world. A 14-day Alaska’s Inside Passage and San Juans Cruise from Seattle to Juneau or reverse costs from $4,695 (Dh17,246), including accommodation, food and most activities. Trips in 2019 start in April and run until September.
FIXTURES
All times UAE ( 4 GMT)
Friday
Saint-Etienne v Montpellier (10.45pm)
Saturday
Monaco v Caen (7pm)
Amiens v Bordeaux (10pm)
Angers v Toulouse (10pm)
Metz v Dijon (10pm)
Nantes v Guingamp (10pm)
Rennes v Lille (10pm)
Sunday
Nice v Strasbourg (5pm)
Troyes v Lyon (7pm)
Marseille v Paris Saint-Germain (11pm)
The biog
Favourite colour: Brown
Favourite Movie: Resident Evil
Hobbies: Painting, Cooking, Imitating Voices
Favourite food: Pizza
Trivia: Was the voice of three characters in the Emirati animation, Shaabiyat Al Cartoon
While you're here...
The Greatest Royal Rumble card
50-man Royal Rumble - names entered so far include Braun Strowman, Daniel Bryan, Kurt Angle, Big Show, Kane, Chris Jericho, The New Day and Elias
Universal Championship Brock Lesnar (champion) v Roman Reigns in a steel cage match
WWE World Heavyweight ChampionshipAJ Styles (champion) v Shinsuke Nakamura
Intercontinental Championship Seth Rollins (champion) v The Miz v Finn Balor v Samoa Joe
United States Championship Jeff Hardy (champion) v Jinder Mahal
SmackDown Tag Team Championship The Bludgeon Brothers (champions) v The Usos
Raw Tag Team Championship (currently vacant) Cesaro and Sheamus v Matt Hardy and Bray Wyatt
Casket match The Undertaker v Rusev
Singles match John Cena v Triple H
Cruiserweight Championship Cedric Alexander v Kalisto
On Women's Day
Dr Nawal Al-Hosany: Why more women should be on the frontlines of climate action
Samar Elmnhrawy: How companies in the Middle East can catch up on gender equality
The National Editorial: Is there much to celebrate on International Women's Day 2021?
Justin Thomas: Challenge the notion that 'men are from Mars, women are from Venus'
On Women's Day
Dr Nawal Al-Hosany: Why more women should be on the frontlines of climate action
Shelina Janmohamed: Why shouldn't a spouse be compensated fairly for housework?
Samar Elmnhrawy: How companies in the Middle East can catch up on gender equality
Justin Thomas: Challenge the notion that 'men are from Mars, women are from Venus'
Results
2.15pm: Maiden (PA) Dh40,000 1,200m
Winner: Maqam, Fabrice Veron (jockey), Eric Lemartinel (trainer).
2.45pm: Maiden (PA) Dh40,000 1,200m
Winner: Mamia Al Reef, Szczepan Mazur, Ibrahim Al Hadhrami.
3.15pm: Handicap (PA) Dh40,000 2,000m
Winner: Jaahiz, Fabrice Veron, Eric Lemartinel.
3.45pm: Handicap (PA) Dh40,000 1,000m
Winner: Qanoon, Szczepan Mazur, Irfan Ellahi.
4.15pm: Sheikh Hamdan bin Rashid Cup Handicap (TB) Dh200,000 1,700m.
Winner: Philosopher, Tadhg O’Shea, Salem bin Ghadayer.
54.45pm: Handicap (PA) Dh40,000 1,700m
Winner: Jap Al Yassoob, Fernando Jara, Irfan Ellahi.
Gulf Under 19s final
Dubai College A 50-12 Dubai College B
The Kites
Romain Gary
Penguin Modern Classics
Company%20profile
On Women's Day
Shelina Janmohamed: Why shouldn't a spouse be compensated fairly for housework?
Samar Elmnhrawy: How companies in the Middle East can catch up on gender equality
The National Editorial: Is there much to celebrate on International Women's Day 2021?
Justin Thomas: Challenge the notion that 'men are from Mars, women are from Venus'
if you go
The flights
Emirates have direct flights from Dubai to Glasgow from Dh3,115. Alternatively, if you want to see a bit of Edinburgh first, then you can fly there direct with Etihad from Abu Dhabi.
The hotel
|
Located in the heart of Mackintosh's Glasgow, the Dakota Deluxe is perhaps the most refined hotel anywhere in the city. Doubles from Dh850 |
Events and tours
There are various Mackintosh specific events throughout 2018 – for more details and to see a map of his surviving designs see glasgowmackintosh.com
For walking tours focussing on the Glasgow Style, see the website of the Glasgow School of Art.
More information
For ideas on planning a trip to Scotland, visit www.visitscotland.com
GAC GS8 Specs
Engine: 2.0-litre 4cyl turbo
Power: 248hp at 5,200rpm
Torque: 400Nm at 1,750-4,000rpm
Transmission: 8-speed auto
Fuel consumption: 9.1L/100km
On sale: Now
Price: From Dh149,900
Who's who in Yemen conflict
Houthis: Iran-backed rebels who occupy Sanaa and run unrecognised government
Yemeni government: Exiled government in Aden led by eight-member Presidential Leadership Council
Southern Transitional Council: Faction in Yemeni government that seeks autonomy for the south
Habrish 'rebels': Tribal-backed forces feuding with STC over control of oil in government territory
Other IPL batting records
Most sixes: 292 – Chris Gayle
Most fours: 491 – Gautam Gambhir
Highest individual score: 175 not out – Chris Gayle (for Royal Challengers Bangalore against Pune Warriors in 2013)
Highest strike-rate: 177.29 – Andre Russell
Highest strike-rate in an innings: 422.22 – Chris Morris (for Delhi Daredevils against Rising Pune Supergiant in 2017)
Highest average: 52.16 – Vijay Shankar
Most centuries: 6 – Chris Gayle
Most fifties: 36 – Gautam Gambhir
Fastest hundred (balls faced): 30 – Chris Gayle (for Royal Challengers Bangalore against Pune Warriors in 2013)
Fastest fifty (balls faced): 14 – Lokesh Rahul (for Kings XI Punjab against Delhi Daredevils in 2018)
'Doctor Strange in the Multiverse Of Madness'
Director: Sam Raimi
Cast: Benedict Cumberbatch, Elizabeth Olsen, Chiwetel Ejiofor, Benedict Wong, Xochitl Gomez, Michael Stuhlbarg and Rachel McAdams
Rating: 3/5
How to avoid crypto fraud
- Use unique usernames and passwords while enabling multi-factor authentication.
- Use an offline private key, a physical device that requires manual activation, whenever you access your wallet.
- Avoid suspicious social media ads promoting fraudulent schemes.
- Only invest in crypto projects that you fully understand.
- Critically assess whether a project’s promises or returns seem too good to be true.
- Only use reputable platforms that have a track record of strong regulatory compliance.
- Store funds in hardware wallets as opposed to online exchanges.
Killing of Qassem Suleimani
National Editorial: Suleimani has been killed, now we must de-escalate
Mina Al Oraibi: Air strike casts a long shadow over the decade ahead
Matthew Levitt: Iran retains its ability to launch terror attacks
Damien McElroy: A CEO tasked with spreading Iran's influence
Hussein Ibish: Trump's order on solid constitutional ground
Simon Waldman: Cautious Israel keeping a low profile
Iftar programme at the Sheikh Mohammed Centre for Cultural Understanding
Established in 1998, the Sheikh Mohammed Centre for Cultural Understanding was created with a vision to teach residents about the traditions and customs of the UAE. Its motto is ‘open doors, open minds’. All year-round, visitors can sign up for a traditional Emirati breakfast, lunch or dinner meal, as well as a range of walking tours, including ones to sites such as the Jumeirah Mosque or Al Fahidi Historical Neighbourhood.
Every year during Ramadan, an iftar programme is rolled out. This allows guests to break their fast with the centre’s presenters, visit a nearby mosque and observe their guides while they pray. These events last for about two hours and are open to the public, or can be booked for a private event.
Until the end of Ramadan, the iftar events take place from 7pm until 9pm, from Saturday to Thursday. Advanced booking is required.
For more details, email openminds@cultures.ae or visit www.cultures.ae
The%C2%A0specs%20
Specs
Engine: 51.5kW electric motor
Range: 400km
Power: 134bhp
Torque: 175Nm
Price: From Dh98,800
Available: Now
SPEC%20SHEET%3A%20APPLE%20IPHONE%2015%20PRO%20MAX
Barcelona 3
Messi (27’, 32’, 87’)
Leganes 1
El Zhar (68’)
Book%20Details
While you're here
Damien McElroy: France has a balancing act to perform – just like it had a century ago
Con Coughlin: Grandstanding in Turkey leads to terrorism in France
Sholto Byrnes: After Charlie Hebdo, is religion dividing the world?